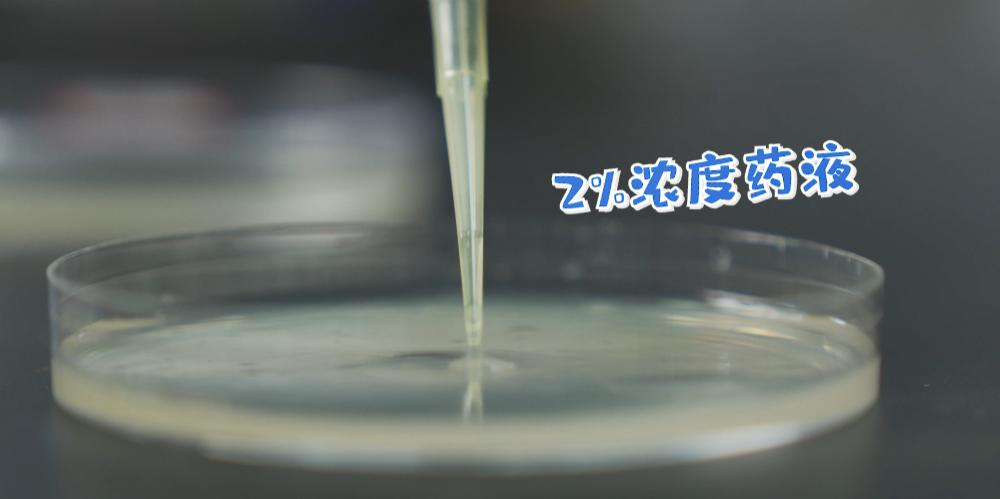

- +1
涨知识|实验告诉你:年纪轻轻的90后是怎么“英年早秃”的
本文专家:袁丞达,杭州市中医院皮肤科副主任医师
原本以为脱发是中老年才会面临的问题。但随着年轻人生活、工作压力不断增大,脱发也开始了年轻化,甚至连90后也加入秃发大军。

好好一个人,怎么说秃就秃了?
我们的头皮,原本是一个相对稳定的小生态系统。其中,有两大主角分别是油脂和真菌。


头屑,一般来说是我们人体的生理代谢。但当经常熬夜、作息不规律、吃的又特别辛辣导致内分泌失调,就会分泌过多的油脂。


“脂溢性皮炎的病人中,年轻人居多。一旦到了夏天,加上熬夜就会使脂溢性皮炎加重。”杭州市中医院皮肤科副主任医师袁丞达说,有些病人因为平时没什么症状,可能只是偶尔脸上会红一下,并没有其他的不舒服,所以就不太注意。
那么如何抑制脂溢性皮炎?
简单!常见的解决方案是使用酮康唑或二硫化硒的洗剂。

“酮康唑 vs 二硫化硒”
第一场 :控油测试
测试前,首先对两名实验员的头皮状况进行检测,通过专业的毛囊检测仪放大五百倍后观察可以看见,两人的头皮状况差不多,都是头屑多、头皮油腻、毛囊堵塞的现象严重。






对抗脂溢性皮炎,最重要的就是抑菌,也就是抑制马拉色菌的增殖和生长。我们在专业的实验室做了一个更直观的实验。
第一步,我们在脂溢性皮炎患者的皮损区刮片取样,接种于培养基中。

拒绝秃头,做好这几点!
首先,减少通宵熬夜,规律的作息和健康的饮食,可以调节内分泌,减少头皮油脂的过多分泌。
其次,可以使用外洗的药物,比如二硫化硒和酮康唑,对局部的真菌繁殖有一定的抑制作用。最新版《亚洲脂溢性皮炎诊疗共识》也首推酮康唑。搭配洗发水使用,防脱又健康。
最后,需要注意的是,脂溢性皮炎的治疗是一个综合治疗。不是单纯用一个药物就能彻底解决,脂溢性皮炎的病程通常比较长,而且很容易反复发作,所以它的治疗是一个长期的过程。
原标题:《年纪轻轻的90后,竟然英年早秃了!实验告诉你,头发是怎么秃的!》
本文为澎湃号作者或机构在澎湃新闻上传并发布,仅代表该作者或机构观点,不代表澎湃新闻的观点或立场,澎湃新闻仅提供信息发布平台。申请澎湃号请用电脑访问http://renzheng.thepaper.cn。





- 报料热线: 021-962866
- 报料邮箱: news@thepaper.cn
互联网新闻信息服务许可证:31120170006
增值电信业务经营许可证:沪B2-2017116
© 2014-2026 上海东方报业有限公司




